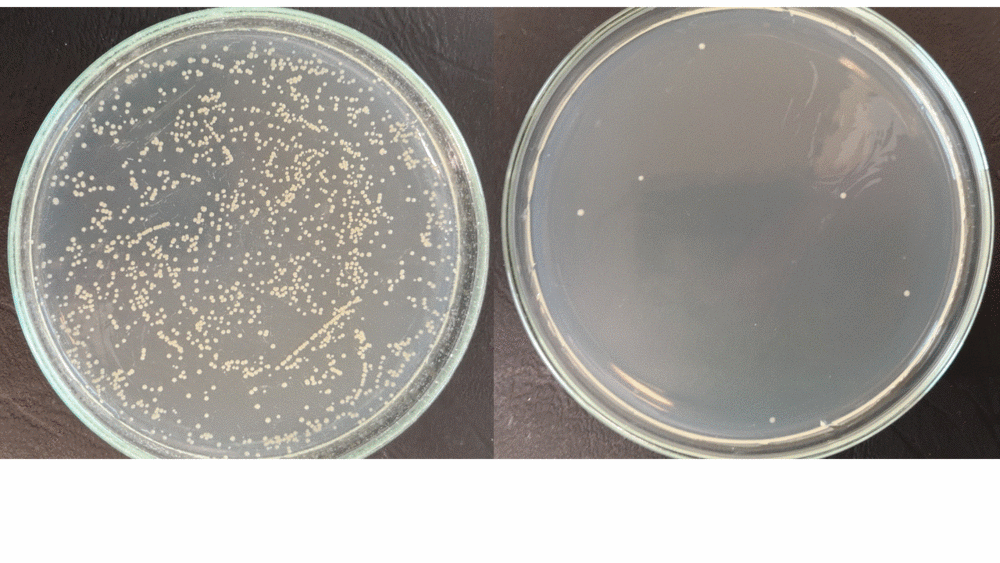
Szalka Petriego przed i po dezynfekcji

Jeszcze przed wybuchem pandemii koronawirusa, brak efektywnych metod dezynfekcji stanowił ogromną trudność w funkcjonowaniu szpitali.
- Robo-UV to zaprojektowany przez City Robotics, robot do odkażania powierzchni. Używa promieniowania ultrafioletowego (UV-C) i może być stosowany do dezynfekcji szpitali na szeroką skalę. Promieniowanie szkodzi człowiekowi, ale robot jest na nie odporny. Co najważniejsze, ta metoda zapewnia niezwykle skuteczne eliminowanie szkodliwych drobnoustrojów - mówi Deepjyoti Nath, współzałożyciel spółki City Robotics.
Mikrobiolodzy z Wydziału Biologii i Ochrony Środowiska Uniwersytetu Łódzkiego uzyskali wstępne wyniki badań nad skutecznością Robo-UV względem patogenów człowieka. Badania wykonane pod koniec listopada w laboratorium Katedry Immunologii i Biologii Infekcyjnej przyniosły bardzo obiecujące wyniki. Robo-UV był przetestowany w zakresie działania bakteriobójczego względem gronkowca złocistego (S. aureus). Drobnoustrój ten może kolonizować naszą skórę, błony śluzowe nosogardzieli ale w szczególnych przypadkach wywoływać trudno leczące się zakażenia ran, patologiczne zmiany nekrotyczne i zapalne, zakażenia bakteryjne związane z biomateriałami czy zakażenia szpitalne.
W badaniach wstępnych mikrobiolodzy wykazali, że bezpośrednia ekspozycja S.aureus na promieniowanie Robo-UV doprowadziła do całkowitego wysterylizowania (zabicia wszystkich drobnoustrojów) już po 3 minutach. Należy zaznaczyć, że do tego eksperymentu wykorzystano jedynie 35% wydajności promieniowania UV (t.j. 2 z 6 lamp UV w prototypie). Wykorzystując pełną wydajność spodziewa się zdecydowanie lepszych rezultatów w zakresie jeszcze większego skrócenia czasu niezbędnego do zabicia mikrobów.
Funkcjonowanie prototypu Robo-UV przerosło oczekiwania i zachęciło twórców Robo-UV do rozszerzenia współpracy z mikrobiologami Wydziału BiOŚ UŁ.
- Naszą współpracę zainicjował Pan Adam Kaźmierczak - dyrektor Centrum Transferu Technologii Uniwersytetu Łódzkiego. Nasz zespół chętnie podejmuje się współpracy z innymi badaczami. Szczególnie inspiruje nas współpraca interdyscyplinarna, a współpraca z informatykami to dla nas debiut. Konfrontowanie pomysłów, terminologii czy samej perspektywy osób z różnych dziedzin nauki otwiera nas na nowe pomysły i wyjście poza standardowe procedury. Mamy nadzieję, że współpraca z Deepjyoti, w zakresie jego wynalazku będzie się rozwijała dalej - komentuje dr Karolina Rudnicka z Katedry Immunologii i Biologii Infekcyjnej WBiOŚ UŁ.
Zgodnie z raportami Europejskiego Centrum ds. Zapobiegania i Kontroli Chorób (ECDC) z 2018 r., ok. 90 000 osób w UE umiera każdego roku na skutek tzw. zakażeń szpitalnych, a Unia Europejska, stawiając czoła temu problemowi, wydaje rocznie ok. 5,5 miliarda euro na walkę z lekoopornymi patogenami człowieka.
- Zapobieganie infekcjom nabywanym w szpitalach jest w tym czasie szczególnie istotne, gdyż pacjenci hospitalizowani z powodu zakażeni wirusem SARS-CoV-2 są bardziej podatni na równoczesne zakażenia innymi mikroorganizmami znajdującymi się w środowisku szpitalnym. Jak pokazuje badanie przeprowadzone na pacjentach z ostrym przebiegu choroby COVID-19 u 40,7% z nich rozwinęły się infekcje towarzyszące nabyte w placówkach szpitalnych. Moim marzeniem jest, aby robot był używany do walki z groźnym wirusem oraz pomocy w ratowaniu ludzkiego życia w tych niepewnych czasach - dodaje Deepjyoti Nath.
Robo-uv walczy z koronawirusem - wynalazek studenta UŁ
Uniwersytet Łódzki to jedna z największych polskich uczelni. Misją UŁ jest kształcenie wysokiej klasy naukowców i specjalistów w wielu dziedzinach humanistyki, nauk społecznych, przyrodniczych, ścisłych, nawet medycznych. UŁ współpracuje z biznesem, zarówno na poziomie kadrowym, zapewniając wykwalifikowanych pracowników, jak i naukowym, oferując swoje know-how przedsiębiorstwom z różnych gałęzi gospodarki. Uniwersytet Łódzki jest uczelnią otwartą na świat - wciąż rośnie liczba uczących się tutaj studentów z zagranicy, a polscy studenci, dzięki programom wymiany, poznają Europę, Azję, wyjeżdżają za Ocean. Uniwersytet jest częścią Łodzi, działa wspólnie z łodzianami i dla łodzian, angażując się w wiele projektów społeczno-kulturalnych.
Zobacz nasze projekty naukowe na https://www.facebook.com/groups/dobranauka/
Tekst: Deepjyoti Nath, dr Karolina Rudnicka
Redakcja: Centrum Promocji UŁ